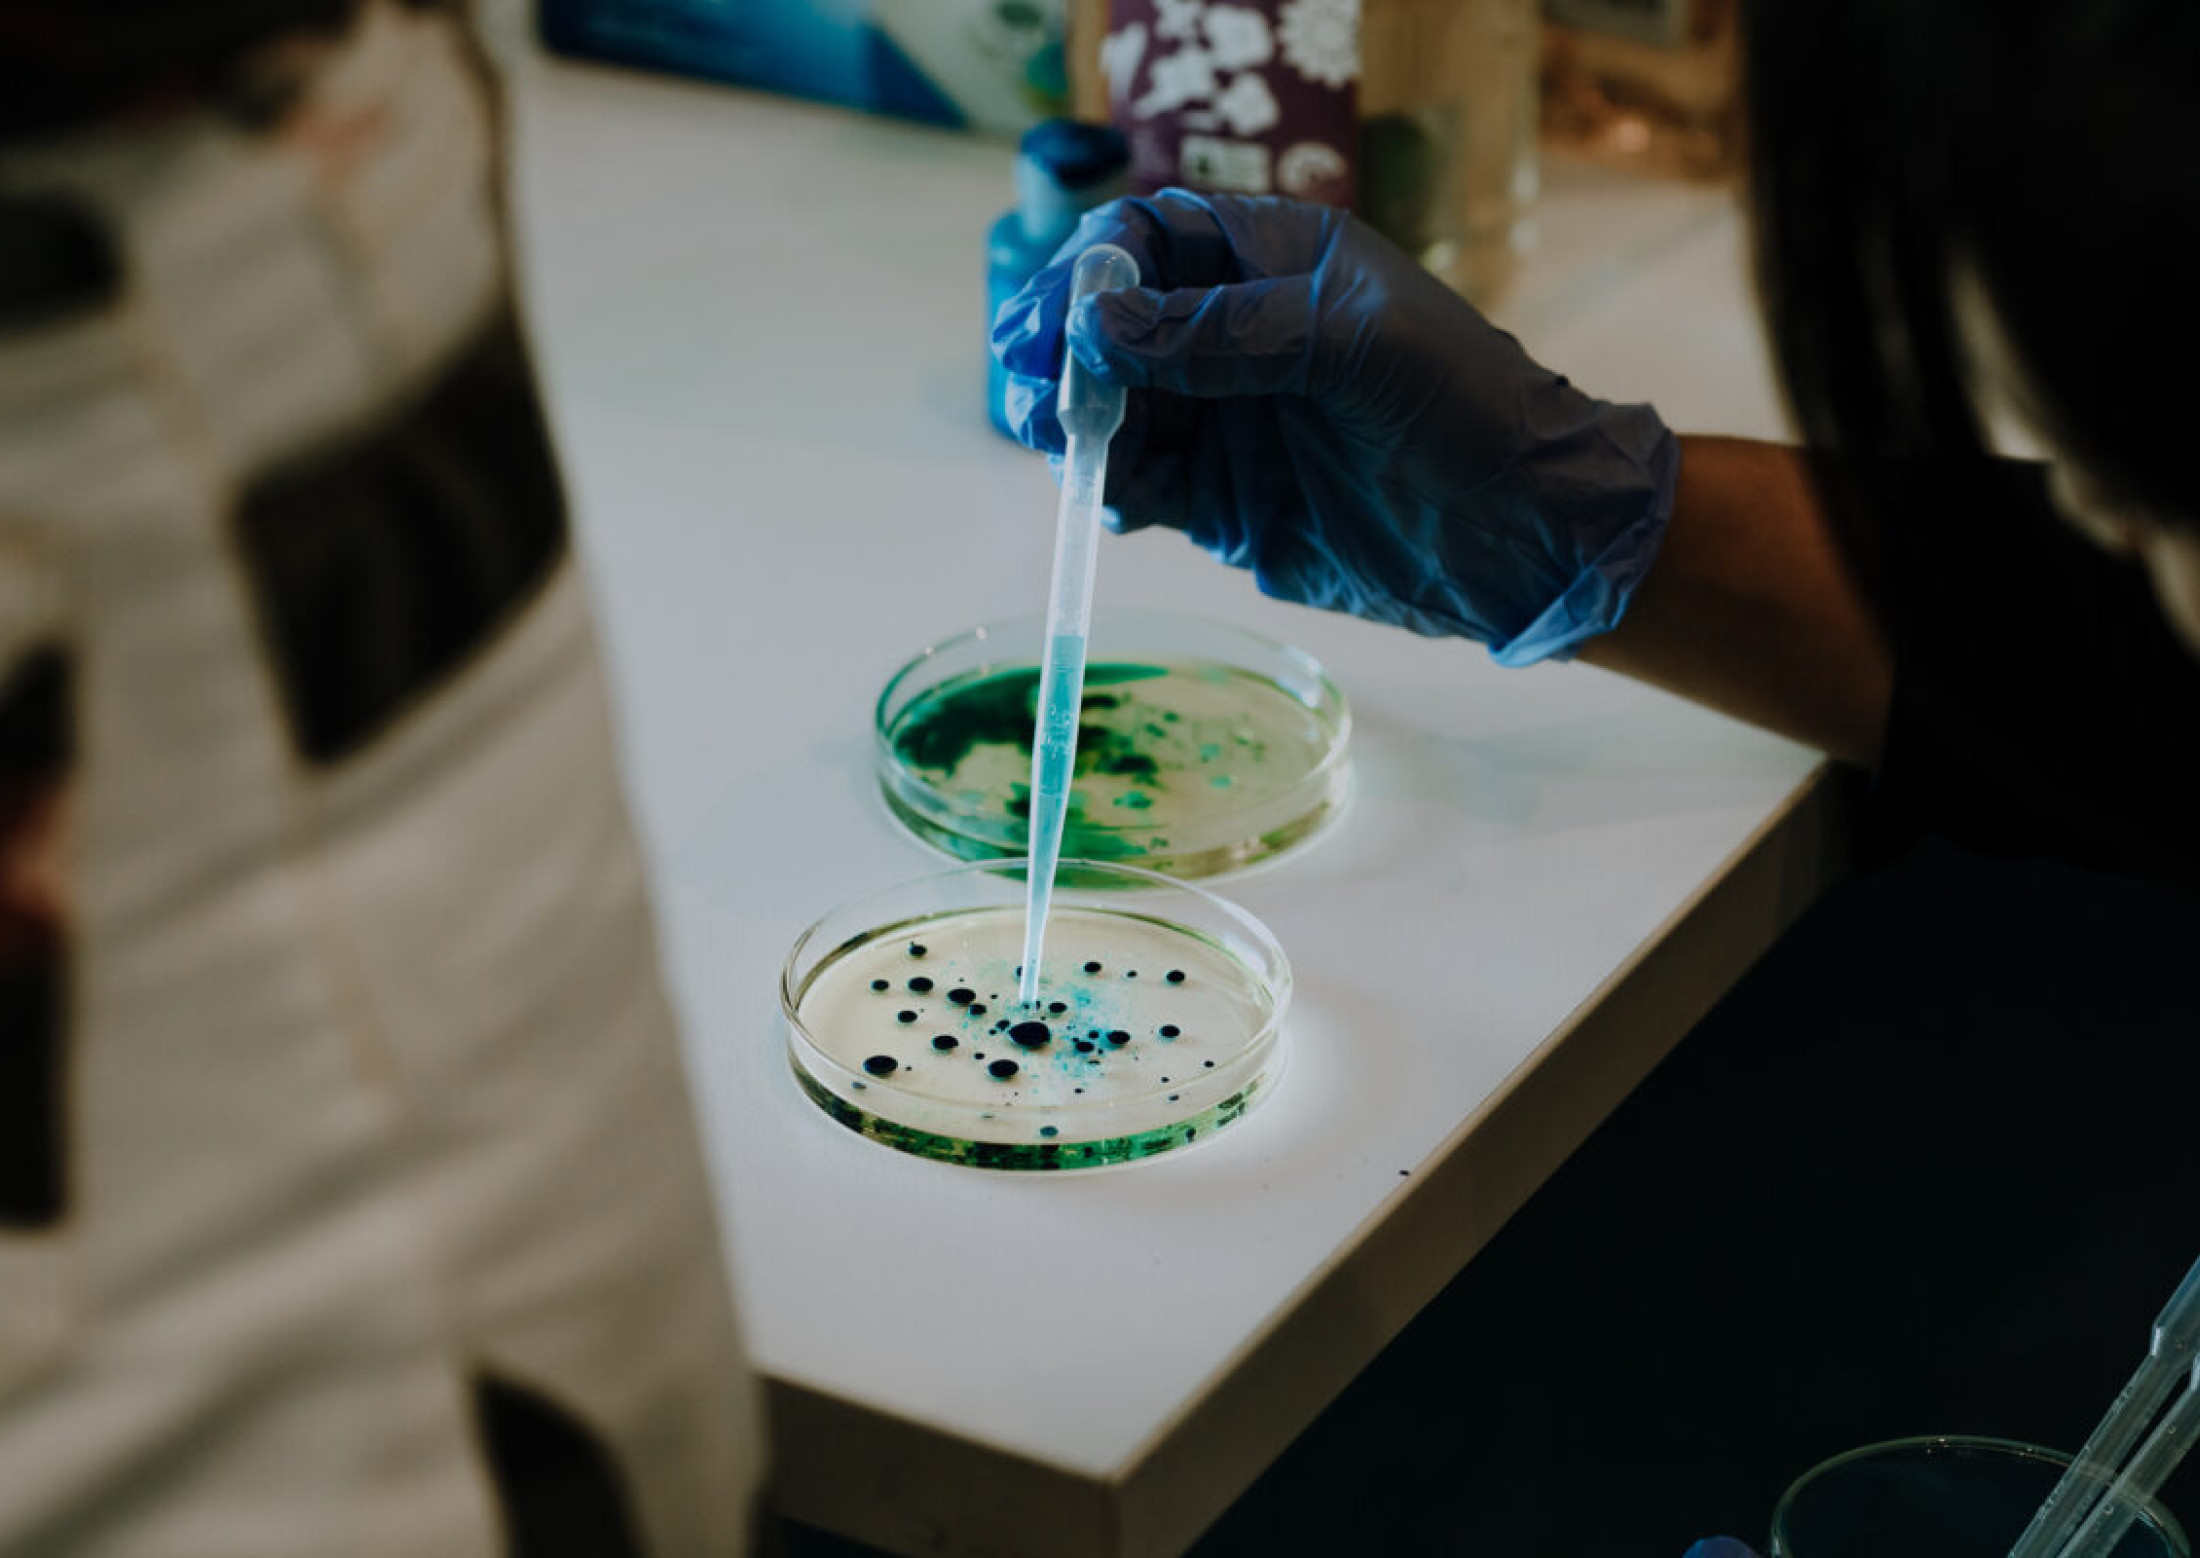
The Wicked Garden

The Wicked Garden was an afternoon workshop and design charrette hosted by special guests Rachel Armstrong and Rolf Hughes (UK) with TCL at our Melbourne studio in October 2018.
The workshop explored an alternative partnership between humanity and the natural world. It asked what the garden for this millennium could be by provoking a reinvention of the languages and tool sets that frame our understanding of the living realm. The workshop provided experimental spaces that can help shape our concepts of metabolism, composting and designing with the living realm.
The workshop drew on the innate complexity and invisible forces of the living world, where participants will explore alternative conversations with nature than those presented by modern discourses on environment and ecology. Drawing from experiments with ‘lively’ matter, participants encountered a simple range of material transformations and techniques that spoke to the ‘wicked’, or irreducible, challenges that are typical of the 21st century.
Rachel Armstrong is Professor of Experimental Architecture at the School of Architecture, Planning and Landscape, Newcastle University, UK.
Rolf Hughes is currently Director of Artistic Research and Experience Design for the Experimental Architecture Group (EAG) at Newcastle University, UK.